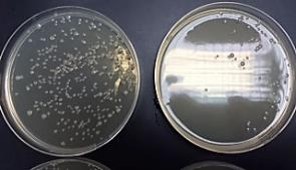
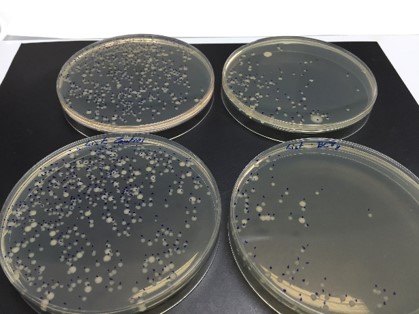

Importante reducción de la carga microbiana
Según distintos trabajos de investigación publicados por muchos autores de distintos países del mundo, y trabajos llevados a cabo por la UPCT, se ha DEMOSTRADO que:
los vapores de aceites esenciales, con dosis aplicadas relativamente bajas consigue una importante reducción de la carga microbiana
(hasta de 7 log10 UFC / 2 cm2)
hasta un nivel indetectable… en la superficie de productos vegetales y otros alimentos sólidos
ESTA ES LA OBSERVACIÓN CIENTÍFICA EN LA QUE SE BASA EL PROCEDIMIENTO DE DESCONTAMINACIÓN SUPERFICIAL DE ALIMENTOS SÓLIDOS PATENTADO QUE SE INCORPORA EN EL SISTEMA DE ENVASADO CLEANPACK
El problema es que no se había desarrollado la manera –la tecnología y la ingeniería correspondiente– de generar estos vapores y de aplicarse a la superficie del alimento y a un ritmo industrial.
ESTO ES LO QUE HA RESUELTO LA TECNOLOGÍA DE ENVASADO CLEANPACK